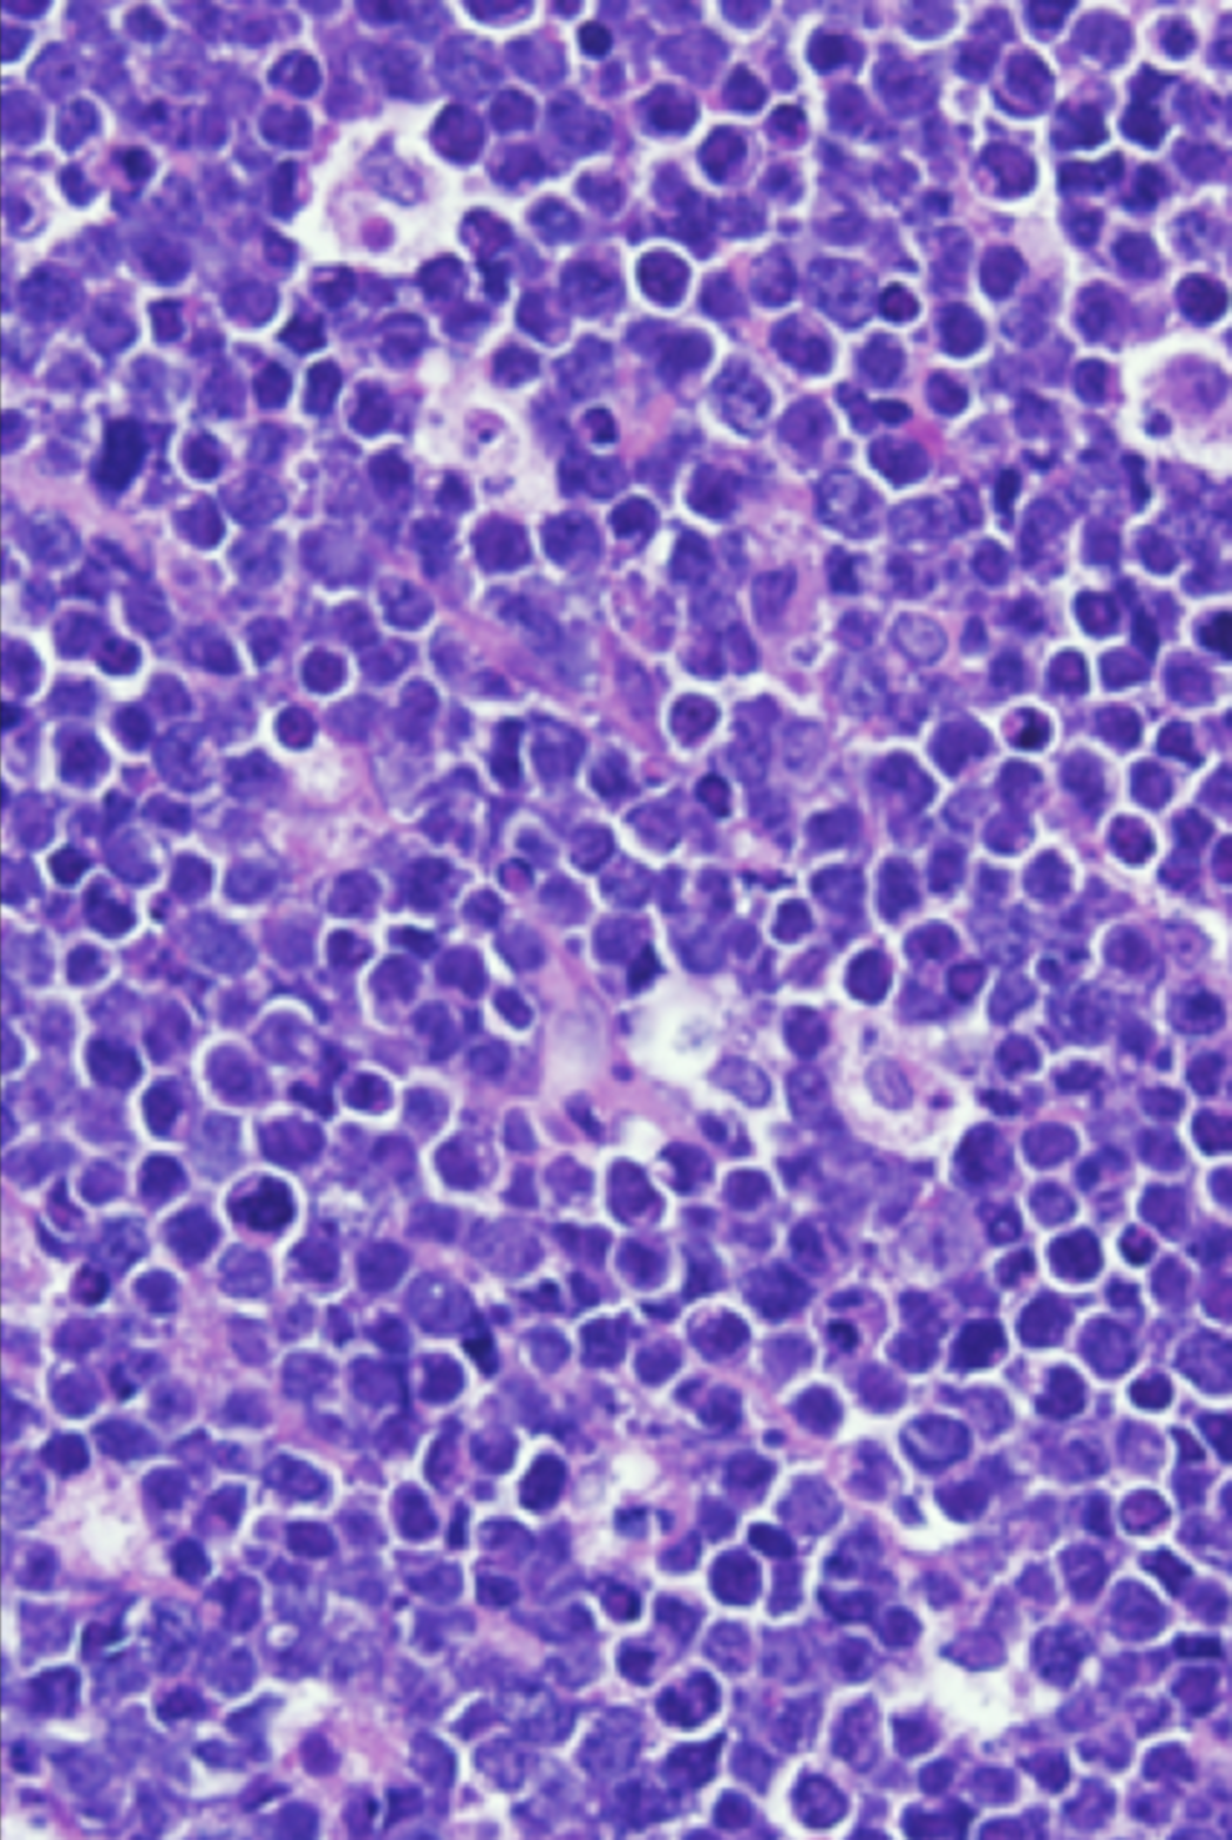
issue cover

Skip Nav Destination
Myeloablative haploidentical BMT with posttransplant cyclophosphamide for hematologic malignancies in children and adults
Ixazomib, dexamethasone, and rituximab in treatment-naive patients with Waldenström macroglobulinemia: long-term follow-up
Clinical and radiologic correlates of neurotoxicity after axicabtagene ciloleucel in large B-cell lymphoma
Delivering HDAC over 3 or 5 days as consolidation in AML impacts health care resource consumption but not outcome
Efficacy of folinic acid rescue following MTX GVHD prophylaxis: results of a double-blind, randomized, controlled study
Impact of donor age and kinship on clinical outcomes after T-cell–replete haploidentical transplantation with PT-Cy
Issue Archive
August 25 2020
In this Issue
Table of Contents
BLOOD ADVANCES TALK
DRUG ADVANCES
STIMULUS REPORT
Platelets mediate serological memory to neutralize viruses in vitro and in vivo
Waltraud C. Schrottmaier,Manuel Salzmann,Sigrun Badrnya,Marion Mussbacher,Julia B. Kral-Pointner,Susanne Morava,Anita Pirabe,Laura Brunnthaler,Koon C. Yaiw,Ulrike M. Heber,David Pereyra,Jan T. Andersen,Andreas Bergthaler,Cecilia Söderberg-Nauclér,Mikael C. I. Karlsson,Alice Assinger,Mattias N. E. Forsell
REVIEW ARTICLE
CLINICAL TRIALS AND OBSERVATIONS
Myeloablative haploidentical BMT with posttransplant cyclophosphamide for hematologic malignancies in children and adults
Clinical Trials & Observations
Heather J. Symons,Marianna Zahurak,Yilin Cao,Allen Chen,Kenneth Cooke,Christopher Gamper,Orly Klein,Nicolas Llosa,Elias T. Zambidis,Richard Ambinder,Javier Bolaños-Meade,Ivan Borrello,Robert Brodsky,Amy DeZern,Ivana Gojo,Margaret Showel,Lode Swinnen,B. Douglas Smith,Leo Luznik,Richard J. Jones,Ephraim J. Fuchs
Ixazomib, dexamethasone, and rituximab in treatment-naive patients with Waldenström macroglobulinemia: long-term follow-up
Clinical Trials & Observations
Jorge J. Castillo,Kirsten Meid,Catherine A. Flynn,Jiaji Chen,Maria G. Demos,Maria L. Guerrera,Amanda Kofides,Xia Liu,Manit Munshi,Nicholas Tsakmaklis,Christopher J. Patterson,Guang Yang,Zachary Hunter,Steven P. Treon
HEALTH SERVICES AND OUTCOMES
Building access to care in adult sickle cell disease: defining models of care, essential components, and economic aspects
Julie Kanter,Wally R. Smith,Payal C. Desai,Marsha Treadwell,Biree Andemariam,Jane Little,Diane Nugent,Susan Claster,Deepa G. Manwani,Judith Baker,John J. Strouse,Ifeyinwa Osunkwo,Rosalyn W. Stewart,Allison King,Lisa M. Shook,John D. Roberts,Sophie Lanzkron
Guideline-based indicators for adult patients with myelodysplastic syndromes
Kristina Stojkov,on behalf of the Swiss MDS Study Group and the Swiss Group of Clinical Cancer Research (SAKK),Tobias Silzle,on behalf of the Swiss MDS Study Group and the Swiss Group of Clinical Cancer Research (SAKK),Georg Stussi,on behalf of the Swiss MDS Study Group and the Swiss Group of Clinical Cancer Research (SAKK),David Schwappach,on behalf of the Swiss MDS Study Group and the Swiss Group of Clinical Cancer Research (SAKK),Juerg Bernhard,on behalf of the Swiss MDS Study Group and the Swiss Group of Clinical Cancer Research (SAKK),David Bowen,on behalf of the Swiss MDS Study Group and the Swiss Group of Clinical Cancer Research (SAKK),Jaroslav Čermák,on behalf of the Swiss MDS Study Group and the Swiss Group of Clinical Cancer Research (SAKK),Avinash G. Dinmohamed,on behalf of the Swiss MDS Study Group and the Swiss Group of Clinical Cancer Research (SAKK),Corien Eeltink,on behalf of the Swiss MDS Study Group and the Swiss Group of Clinical Cancer Research (SAKK),Sabrina Eggmann,on behalf of the Swiss MDS Study Group and the Swiss Group of Clinical Cancer Research (SAKK),Pierre Fenaux,on behalf of the Swiss MDS Study Group and the Swiss Group of Clinical Cancer Research (SAKK),Ulrich Germing,on behalf of the Swiss MDS Study Group and the Swiss Group of Clinical Cancer Research (SAKK),Manuel Haschke,on behalf of the Swiss MDS Study Group and the Swiss Group of Clinical Cancer Research (SAKK),Eva Hellstrom-Lindberg,on behalf of the Swiss MDS Study Group and the Swiss Group of Clinical Cancer Research (SAKK),Monika Heger,on behalf of the Swiss MDS Study Group and the Swiss Group of Clinical Cancer Research (SAKK),Arjan A. van de Loosdrecht,on behalf of the Swiss MDS Study Group and the Swiss Group of Clinical Cancer Research (SAKK),Jakob Passweg,on behalf of the Swiss MDS Study Group and the Swiss Group of Clinical Cancer Research (SAKK),Michael Pfeilstöcker,on behalf of the Swiss MDS Study Group and the Swiss Group of Clinical Cancer Research (SAKK),Uwe Platzbecker,on behalf of the Swiss MDS Study Group and the Swiss Group of Clinical Cancer Research (SAKK),Luca Malcovati,on behalf of the Swiss MDS Study Group and the Swiss Group of Clinical Cancer Research (SAKK),António Medina de Almeida,on behalf of the Swiss MDS Study Group and the Swiss Group of Clinical Cancer Research (SAKK),Moshe Mittelman,on behalf of the Swiss MDS Study Group and the Swiss Group of Clinical Cancer Research (SAKK),Christine Morgenthaler,on behalf of the Swiss MDS Study Group and the Swiss Group of Clinical Cancer Research (SAKK),David P. Steensma,on behalf of the Swiss MDS Study Group and the Swiss Group of Clinical Cancer Research (SAKK),Valeria Santini,on behalf of the Swiss MDS Study Group and the Swiss Group of Clinical Cancer Research (SAKK),Reinhard Stauder,on behalf of the Swiss MDS Study Group and the Swiss Group of Clinical Cancer Research (SAKK),Argiris Symeonidis,on behalf of the Swiss MDS Study Group and the Swiss Group of Clinical Cancer Research (SAKK),Sämi Schär,on behalf of the Swiss MDS Study Group and the Swiss Group of Clinical Cancer Research (SAKK),Charlotte Maddox,on behalf of the Swiss MDS Study Group and the Swiss Group of Clinical Cancer Research (SAKK),Theo de Witte,on behalf of the Swiss MDS Study Group and the Swiss Group of Clinical Cancer Research (SAKK),Julia Bohlius,on behalf of the Swiss MDS Study Group and the Swiss Group of Clinical Cancer Research (SAKK),Nicolas Bonadies,on behalf of the Swiss MDS Study Group and the Swiss Group of Clinical Cancer Research (SAKK)
IMMUNOBIOLOGY AND IMMUNOTHERAPY
Human NK cells prime inflammatory DC precursors to induce Tc17 differentiation
Maria A. Clavijo-Salomon,Rosalba Salcedo,Soumen Roy,Rodrigo X. das Neves,Amiran Dzutsev,Helioswilton Sales-Campos,Karen Steponavicius-Cruz Borbely,Lucia Silla,Jordan S. Orange,Emily M. Mace,José A. M. Barbuto,Giorgio Trinchieri
LYMPHOID NEOPLASIA
Clinical and radiologic correlates of neurotoxicity after axicabtagene ciloleucel in large B-cell lymphoma
Clinical Trials & Observations
Paolo Strati,Loretta J. Nastoupil,Jason Westin,Luis E. Fayad,Sairah Ahmed,Nathan H. Fowler,Fredrick B. Hagemeister,Hun J. Lee,Swaminathan P. Iyer,Ranjit Nair,Simrit Parmar,Maria A. Rodriguez,Felipe Samaniego,Raphael E. Steiner,Michael Wang,Chelsea C. Pinnix,Sherry Adkins,Catherine M. Claussen,Charles S. Martinez,Misha C. Hawkins,Nicole A. Johnson,Prachee Singh,Haleigh E. Mistry,Sandra Horowitz,Shirley George,Lei Feng,Partow Kebriaei,Elizabeth J. Shpall,Sattva S. Neelapu,Sudhakar Tummala,T. Linda Chi
Allogeneic stem cell transplantation for chronic lymphocytic leukemia in the era of novel agents
Lindsey E. Roeker,Peter Dreger,Jennifer R. Brown,Oscar B. Lahoud,Toby A. Eyre,Danielle M. Brander,Alan Skarbnik,Catherine C. Coombs,Haesook T. Kim,Matthew Davids,Steven T. Manchini,Gemlyn George,Nirav Shah,Timothy J. Voorhees,Kim H. Orchard,Harriet S. Walter,Arvind K. Arumainathan,Andrea Sitlinger,Jae H. Park,Mark B. Geyer,Andrew D. Zelenetz,Craig S. Sauter,Sergio A. Giralt,Miguel-Angel Perales,Anthony R. Mato
MYELOID NEOPLASIA
Delivering HDAC over 3 or 5 days as consolidation in AML impacts health care resource consumption but not outcome
Clinical Trials & Observations
Pierre-Yves Dumas,Sarah Bertoli,Emilie Bérard,Thibaut Leguay,Suzanne Tavitian,Jean Galtier,Camille Alric,Audrey Bidet,Eric Delabesse,Jean Baptiste Rieu,Jean-Philippe Vial,François Vergez,Nicolas Lechevalier,Isabelle Luquet,Emilie Klein,Audrey Sarry,Héloïse Rey,Anne-Charlotte de Grande,Fabien Despas,Arnaud Pigneux,Christian Récher
RED CELLS, IRON, AND ERYTHROPOIESIS
Neutrophils from hereditary hemochromatosis patients are protected from iron excess and are primed
Cyril Renassia,Sabine Louis,Sylvain Cuvellier,Nadia Boussetta,Jean-Christophe Deschemin,Didier Borderie,Karine Bailly,Joel Poupon,Pham My-Chan Dang,Jamel El-Benna,Sandra Manceau,François Lefrère,Sophie Vaulont,Carole Peyssonnaux
TRANSFUSION MEDICINE
Biological and structural characterization of murine TRALI antibody reveals increased Fc-mediated complement activation
Eveline A. N. Zeeuw van der Laan,Saskia van der Velden,Arthur E. H. Bentlage,Mads D. Larsen,Thijs L. J. van Osch,Juk Yee Mok,Giso Brasser,Dionne M. Geerdes,Carolien A. M. Koeleman,Jan Nouta,John W. Semple,Leendert Porcelijn,Wim J. E. van Esch,Manfred Wuhrer,C. Ellen van der Schoot,Gestur Vidarsson,Rick Kapur
TRANSPLANTATION
Efficacy of folinic acid rescue following MTX GVHD prophylaxis: results of a double-blind, randomized, controlled study
Clinical Trials & Observations
Moshe Yeshurun,Uri Rozovski,Oren Pasvolsky,Ofir Wolach,Ron Ram,Odelia Amit,Tsila Zuckerman,Anat Pek,Maly Rubinstein,Michal Sela-Navon,Pia Raanani,Liat Shargian-Alon
Impact of donor age and kinship on clinical outcomes after T-cell–replete haploidentical transplantation with PT-Cy
Clinical Trials & Observations
Jacopo Mariotti,Anna Maria Raiola,Andrea Evangelista,Angelo Michele Carella,Massimo Martino,Francesca Patriarca,Antonio Risitano,Stefania Bramanti,Alessandro Busca,Luisa Giaccone,Lucia Brunello,Emanuela Merla,Lucia Savino,Barbara Loteta,Giuseppe Console,Renato Fanin,Alessandra Sperotto,Luana Marano,Serena Marotta,Camilla Frieri,Simona Sica,Patrizia Chiusolo,Samia Harbi,Sabine Furst,Armando Santoro,Andrea Bacigalupo,Didier Blaise,Emanuele Angelucci,Domenico Mavilio,Luca Castagna,Benedetto Bruno
COMMENTARY
ERRATUM
-
Cover Image
Cover Image
![issue cover]()
COVER FIGURE
Tumor histology from a child with Burkitt lymphoma. See the article by Ozuah et al. - PDF Icon Front MatterFront Matter
- PDF Icon Editorial BoardEditorial Board
Advertisement intended for health care professionals
Advertisement intended for health care professionals